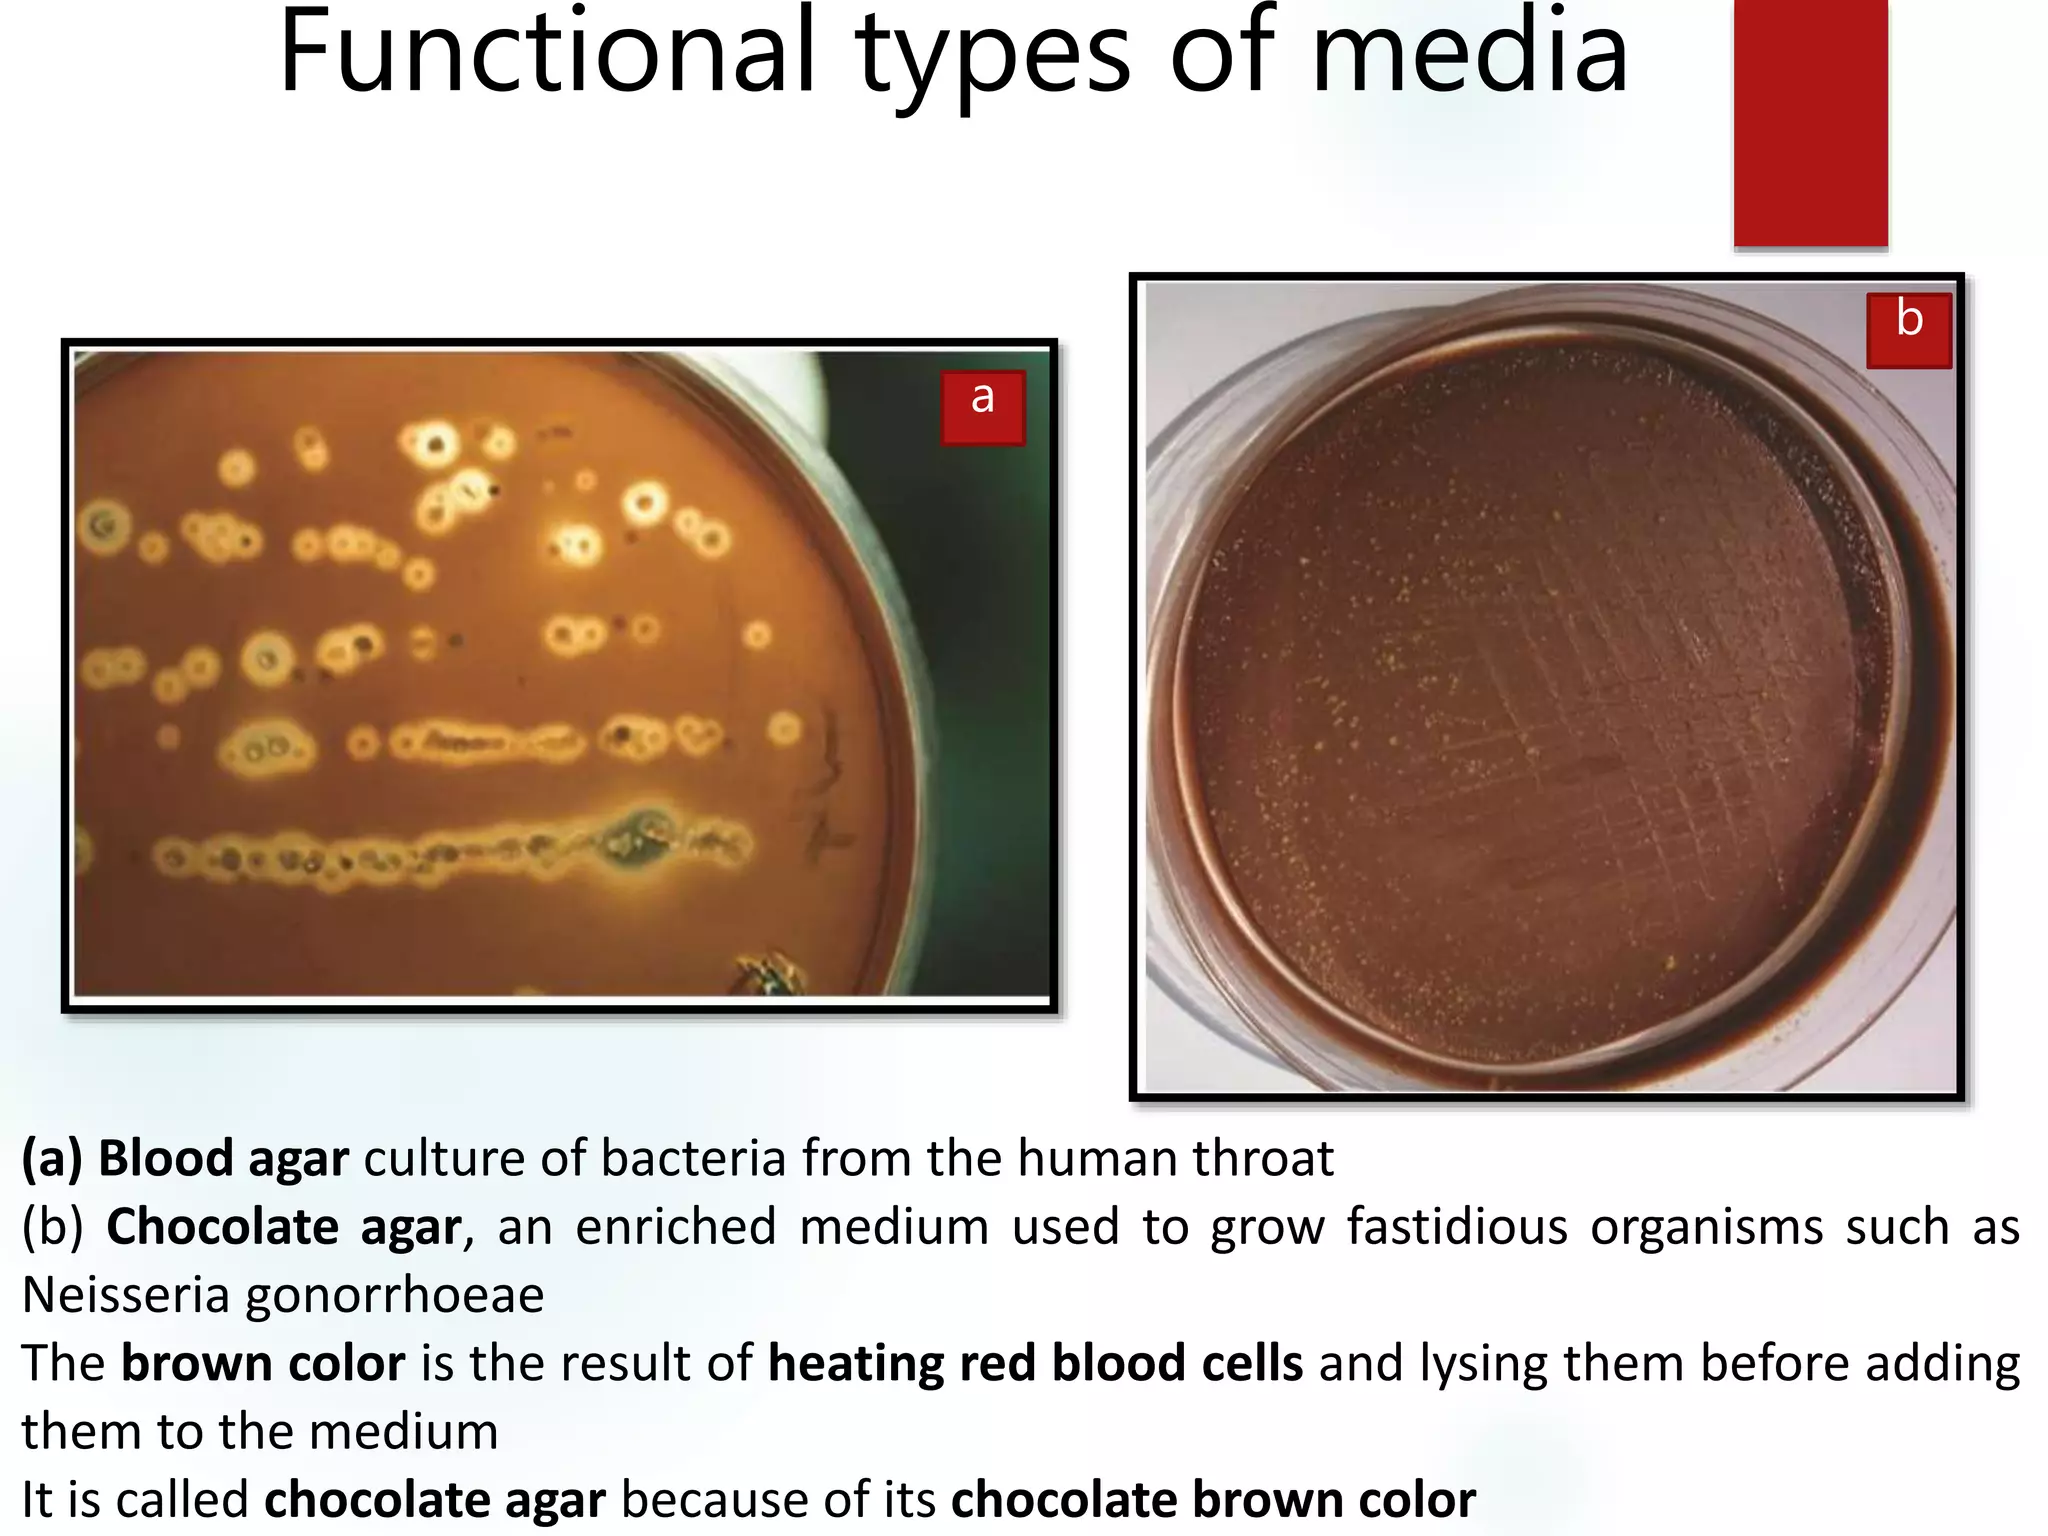
Functional types of media
(a) Blood agar culture of bacteria from the human throat
(b) Chocolate agar, an enriched medium used to grow fastidious organisms such as
Neisseria gonorrhoeae
The brown color is the result of heating red blood cells and lysing them before adding
them to the medium
It is called chocolate agar because of its chocolate brown color
a
b
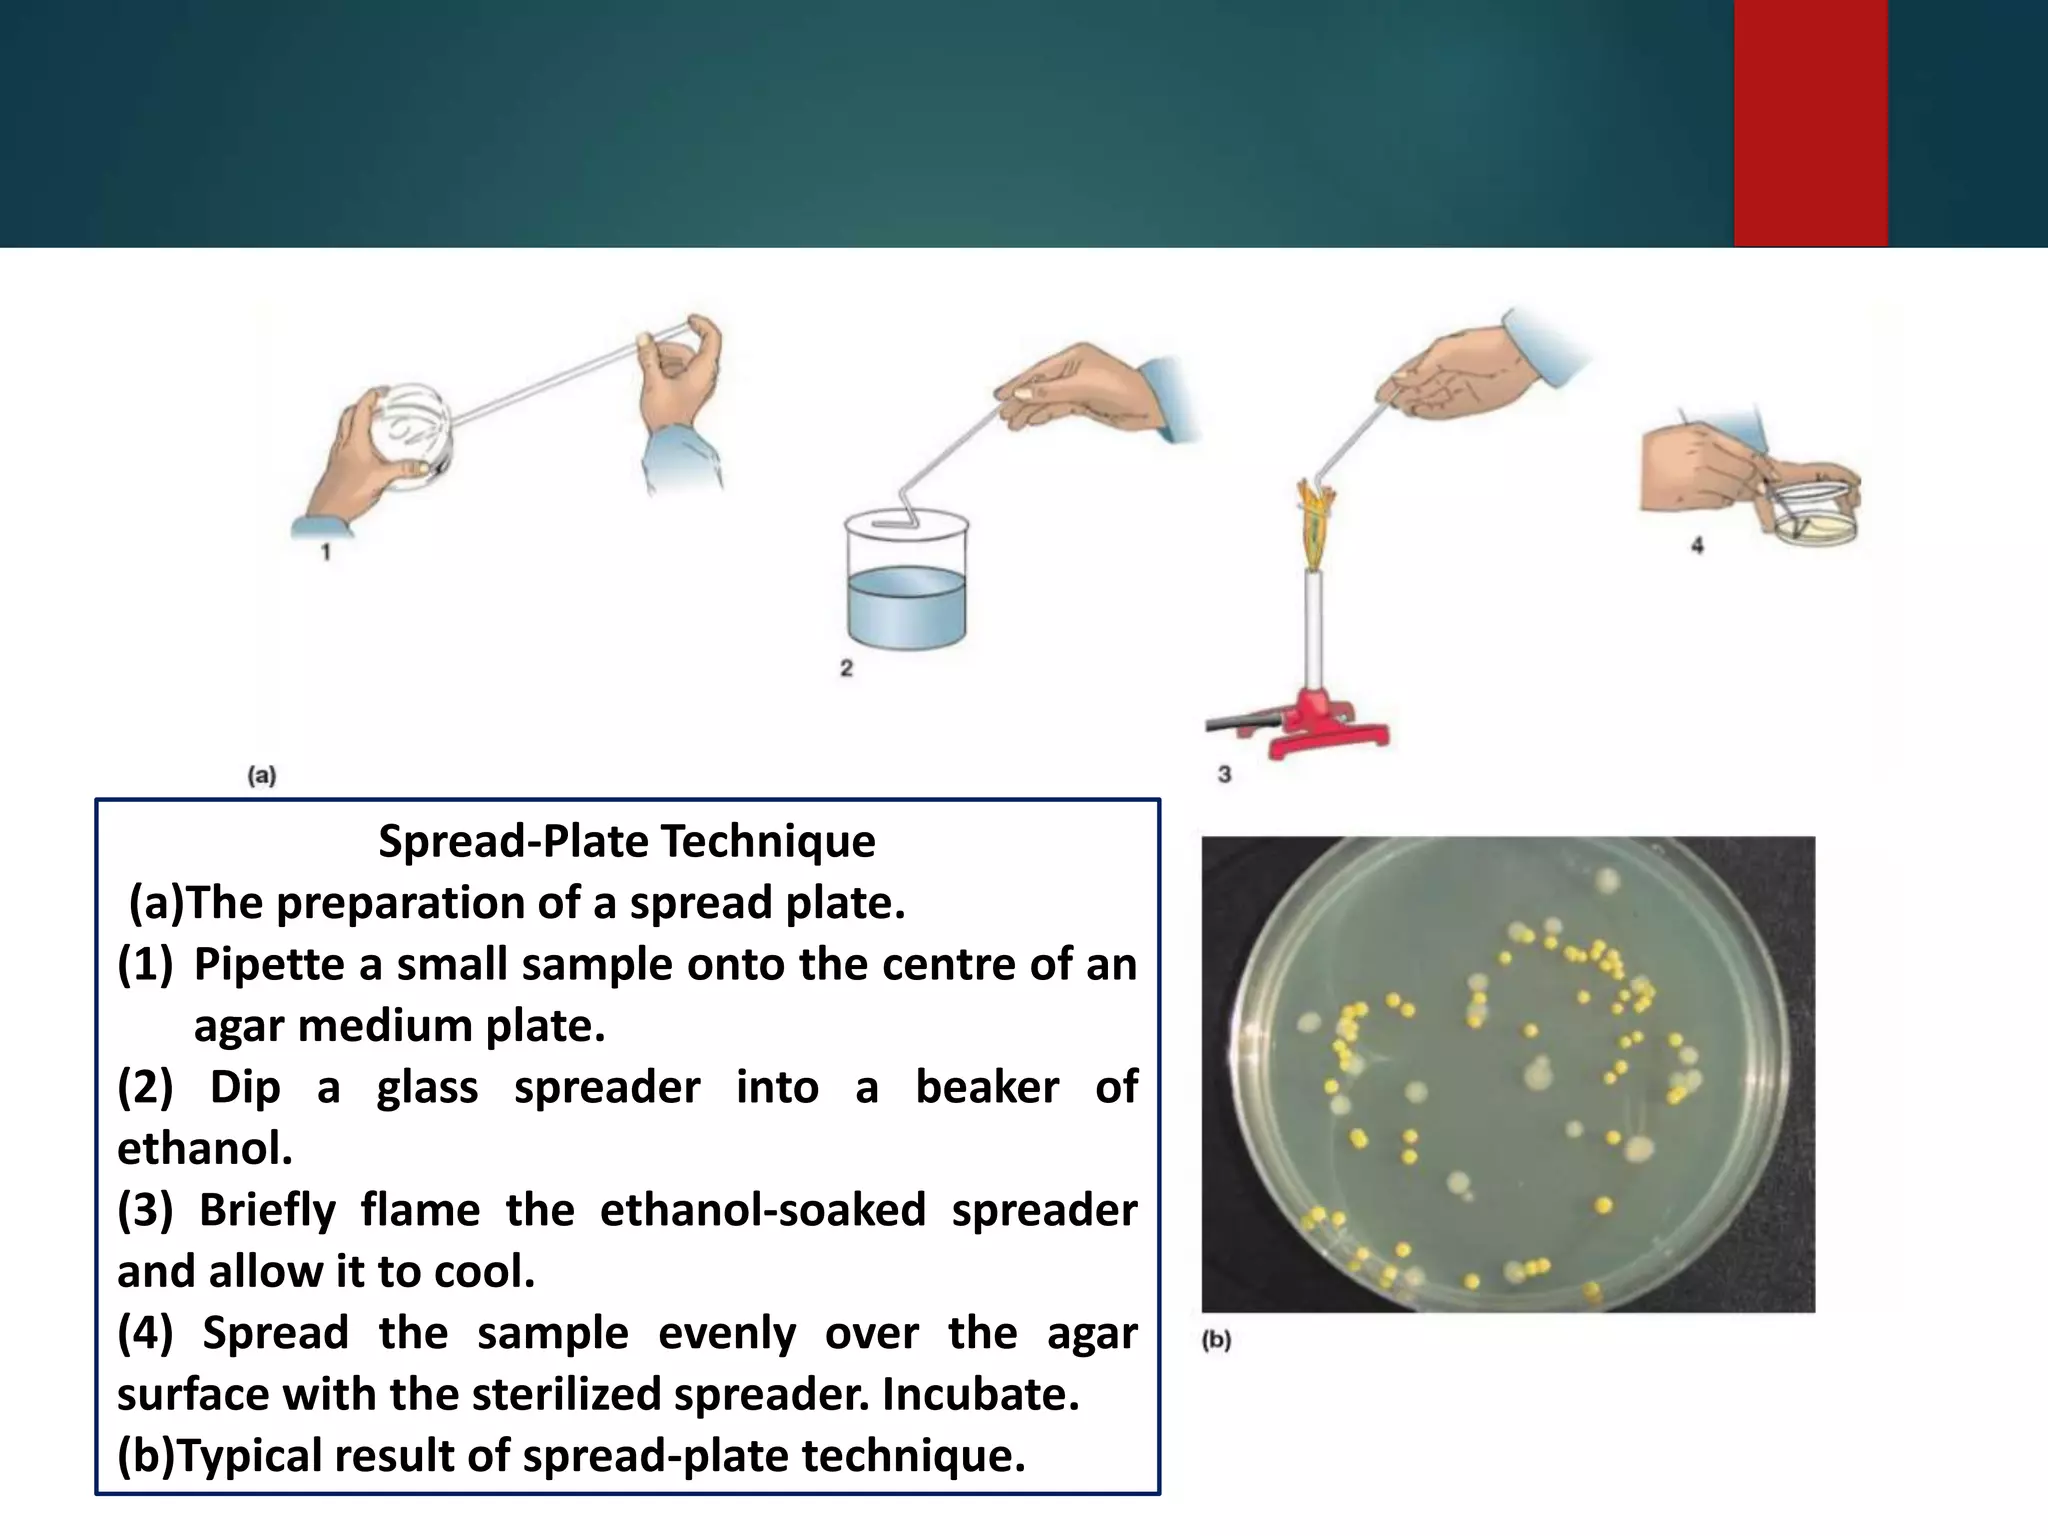
Spread-Plate Technique
(a)The preparation of a spread plate.
(1) Pipette a small sample onto the centre of an
agar medium plate.
(2) Dip a glass spreader into a beaker of
ethanol.
(3) Briefly flame the ethanol-soaked spreader
and allow it to cool.
(4) Spread the sample evenly over the agar
surface with the sterilized spreader. Incubate.
(b)Typical result of spread-plate technique.
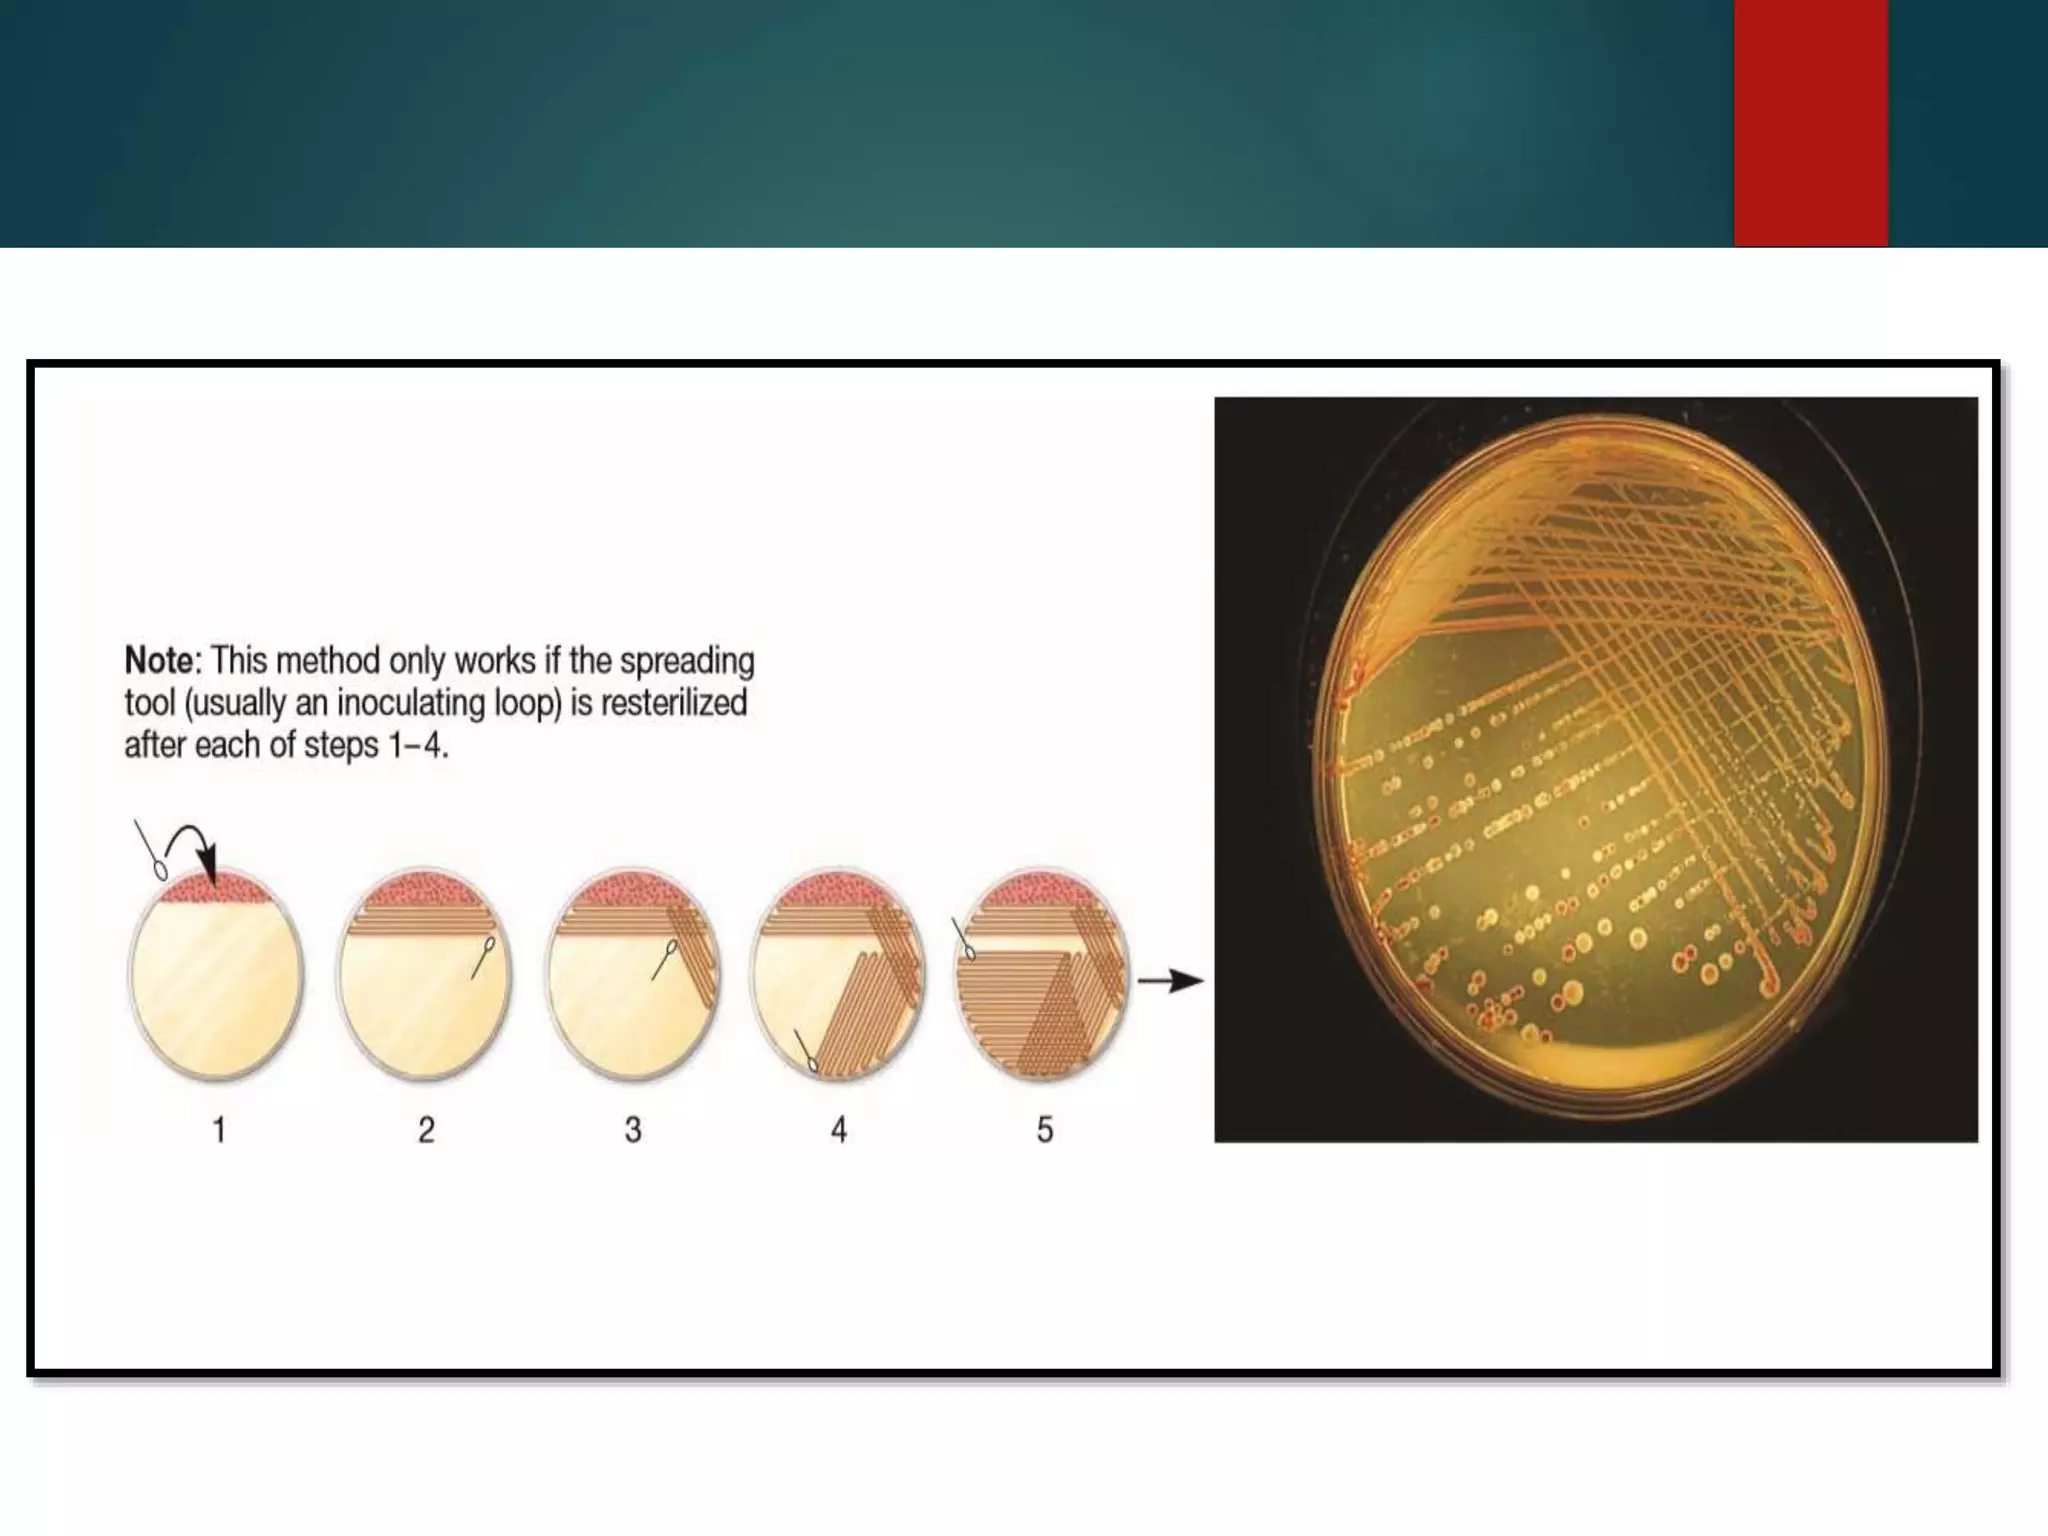
A typical streaking pattern is shown

Nutrients are required for microbial growth and act as building blocks and energy sources. The main nutrient requirements for microorganisms include carbon, nitrogen, phosphorus, sulfur, hydrogen, oxygen, potassium, calcium, magnesium, iron and trace elements. Microorganisms can be classified based on their carbon, energy and electron sources as photolithotrophs, photoorganoheterotrophs, chemolithoautotrophs, chemolithoheterotrophs or chemoorganoheterotrophs. Culture media are used to grow microorganisms and include defined, complex, liquid, solid, supportive, enriched, selective and differential media depending on their composition and purpose.